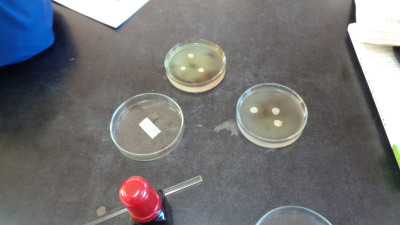
DSC08408

2、3年理科では、合同で生態系のバランスを体感できるゲームを行いました。まずは、シカ役(捕食者)とえさ役(被食者)に分かれ、同時に「水・すみか・えさ」のどれかのポーズをします。同じポーズのえさ役をシカ役が捕まえます。捕まったえさ役は次の回からシカ役となります。





食物連鎖における個体数の変化についてゲームの結果から考察すると、生物の数は増減を繰り返すことがわかりました。では、そこに人間が加わるとどう変化するのか。ゲームを通して大きな気づきを得ることができました。
1年社会 アメリカの文化
先生が書いたスターバックスのマークがあまりにも上手くて、大喜びしていました。


1・2年学活 予餞会の準備
1・2年生は合同で、予餞会の準備を進めています。






椎の木生活単元 ポンポン作り
できあがったものがだんだん増えてきました。今日はそれにつけるパーツを考えたり、文を考えたりしていました。


椎の木理科 演習問題
入試に向けて対策を進めています。復習を繰り返して、身につけていきます。


3年数学 P+Q=Rが常に成り立つことを証明しよう
以前に習ったことも、復習をすると「そうだったのか」とわかることがあります。あきらめずにチャレンジしていこう。


天気予報図はまさに典型的な冬型、青空は広がりますが、空っ風が強く、寒い一日です。
6時間目は合同体育です。学年ごとに練習してきたバレーボール、今日はゲーム練習です。本校は各学年の人数が少ないので、こうして計画的に学年を超えた交流により、普段とは違う賑やかな雰囲気で運動を楽しめるようにしています。







一体感が生まれ学校全体での人間関係が豊かになるとともに、戦術的な幅や対応力が向上します。少人数の学校だからこそ、できることだと感じます。
1年英語 「Who+動詞~?」「Whose+名詞~?」誰、誰の、を尋ねる言い方
この言い方は、使える場面が多いと思います。積極的に使ってみてください。


1年技術 横置き本立て
のこぎりで切った後を丸く削る作業、相当根気がいると思いましたが、「あきらめません!」ときっぱり。


2年数学 直角三角形はどんな場合に合同になるのか証明しよう
図形を線対称や点対称の配置にすると、非常にわかりやすくなりました。


2年家庭 調理実習のまとめ
調理実習以降、習った生姜焼きなど家族に振る舞うことができたのかな?


椎の木作業 ポンポン作り
2時間連続で、一生懸命作業に取り組んでいました。


3年理科 生物の遺骸のゆくえ
微生物がデンプンを食べてくれたことがよくわかった実験でした。

3年英語 演習問題
わからないところは、遠慮せず、学校で解決していきましょう。


本校の卒業生である書道家・小林みどり先生をお招きし、書き初め練習会を行いました。小林先生は、生徒一人ひとりの名前を事前に書いてきてくださいました。 「名前は一生使うものだから」という先生の温かいお心遣いから、心のこもった特別なお手本を用意してくださったそうです。流れるような、うっとりするほど美しい筆の運びで書かれた生徒の名前を前に、生徒たちは真剣な眼差しで筆を握りました。先生の丁寧なご指導のもと、一筆一筆集中して書き上げました。
3年生の様子




1年生の様子



2年生の様子



伝統的な日本の文化である書道の奥深さに触れるとともに、小林先生の卒業生としての深い愛情とプロの技に感動しました。小林先生、今日一日、大変丁寧にご指導くださり、ありがとうございました。
1年英語 「Which+名詞~?」「Why~?」の文
発音練習をしていました。「sea」と「she」の発音の違いもわかったかな?


2年数学 正三角形になる条件を説明しよう
難しい問題に頭を悩ませていました。行き詰まった時に素直に「教えて!」と頼れる友達がいるのは、素敵なことですね。


3年技術 情報学習
私たちは大量の情報に触れています。この時、最も重要になるのが、「どうやって検索すると、知りたい情報にいち早く行き着けるのか」を知ることです。


来週も、元気なみなさんに会えますように。
午後から、生徒集会を実施しました。このために各委員会の委員長・副委員長は、昼休みなどを使ってスライド作成や、報告のアナウンスを練習してきました。声も通って、とてもわかりやすく発表でした。
保健衛生委員会

生活改善委員会

歌声放送委員会


集会の後半は、昨日に続き、ボッチャ大会の試合を行いました。昨日、実際にプレイしたことで、格段に上達しており、試合は劇的な逆転劇の連続でした。狙い澄ましたスーパープレイに大いに盛り上がる班も見られました。






2日間のボッチャ大会で、生徒同士の距離が一層縮まったのを感じられる、素晴らしい時間となりました。生徒会役員のみなさん、素敵な時間をありがとうございました。
1年数学 単元テスト
第4回目の単元テストです。これが終われば楽しいボッチャ大会が待っている?!


1年英語 英語クイズ
2班での対抗戦。大きく引き離されていましたが、最後に残ったカードで200点をゲットし大逆転!


2年理科 単元テスト「電流の性質」
こつこつと頑張っていました。電流は生活に密着しているので、しっかり理解してね。


2年社会 開国と近代日本の歩み
歴史の流れをつかむと、なぜそうなっていったのかがわかります。先生の説明もわかりやすいですね。


椎の木自立活動 英語学習
二人の対決でした。さて、勝利の女神はどちらに微笑んだのでしょうか。


椎の木社会 地理の学習
日本全国を8つに分けた「八地方区分」について学習していました。


3年数学 演習問題
受験を意識して、取り組んでいます。このメンバー全員で受験を乗り越えましょうね。


3年英語 演習問題
全問正解の笑顔。毎日、朝勉強に頑張った成果が現れてきていますね。


本埜小学校の児童の皆さんと、「ふれあい交流会 ボッチャ大会」を開催しました。「共生(きょうせい)」とは、「みんなが、そのままの自分で、一緒に、楽しく暮らすこと」だと考えています。これは、社会全体、そして一人ひとりが幸せになるために、とても大切なことです。
今日のボッチャでは、みんなが「ちがうやり方」で投げたように、その違いこそが「そのままの自分」です。皆さんがありのままの自分を受け入れ、友達と楽しく過ごせたなら、これほど嬉しいことはありません。【「地域との交流」にもっと多くの写真を載せてあります。ご覧ください。】
椎の木
今日にふれあい交流会では、みんなの中心となって準備をしたり、進行したりしました。楽しい時間をありがとうございました。





水曜日はどの学年も音楽と美術のある日です。アートに没頭して、感性を磨いてほしいと考えています。
1年~3年音楽 「いのちの歌」






1~3年美術 お面作り・木彫・篆刻






午後には、2年生による職場体験学習の報告発表会を実施しました。発表会には1年生も参加し、上級生が実際にどのような場所で、どのような活動を経験してきたのかについて、真剣な眼差しで耳を傾けている様子が見られました。
2年生は、体験を通して得た学びや、働くことの意義について、写真や感想を交えながら、下級生にも分かりやすく伝えました。この発表は、1年生が来年体験学習に取り組む上での参考となり、また全生徒にとって職業観を養う良い機会となりました。
















急なお知らせにもかかわらず、多くの保護者の方がご参観くださり、生徒たちの大きな励みになったことと思います。どうもありがとうございました。
3年生を対象に印旛給食センターの羽生栄養士による「受験期の食事」に関する食育指導を実施しました。特に、朝食と学力の関係が注目を集めました。学力調査のデータによると、朝食を食べている生徒と食べていない生徒の間には、国・数・英でそれぞれ平均10点以上の差があり、特に数学では17.6点もの大差があることが示されました。生徒たちは、体調と集中力の維持に朝食が不可欠であることを再認識しました。


受験期の食事の3つのポイントです。意識して取り組みましょう。

講話の最後に、献立のリクエストを聞いてくださいました。パンナコッタ、はちみつレモンゼリー、からあげ。ぶりフライという人もいました。確かにおいしいですね。
1年理科 物質が状態変化するときの体積と質量の変化
固体のとき、液体のとき、それぞれの変化はどうでしたか?


1年社会 単元テスト
そうっと入っていくと、「カリカリ・・・」と鉛筆を走らせる音が聞こえてきました。よく勉強していますね。


2年国語 書き初め 自分の名前を行書で書こう
「今日は鉛筆で書いてみよう。」先生のお手本をガラス窓に透かして写し取り、練習する工夫も見られました。


2年英語 Lesson6-1
WORD ATTACKをやっていました。練習に勝るものはない。語彙量を増やしていきましょう。


椎の木数学 実践問題
「復習テストが満点でした。」と、笑顔の担任の先生。昨日頑張った復習の成果でしょう。

椎の木理科
入試に向けて問題をこなしていました。範囲をまんべんなく学習。Eライブラリを活用しています。


3年理科 微生物のはたらきについて調べよう
泥水の中には、どんな微生物がいたのでしょうか。見つかりましたか?


3年社会 流通の役割について考えよう
「もし流通がなかったら」あなたはどう考えましたか?流通のおかげで、今の豊かで安全な生活を築いていることを再認識しました。


今朝は、うっすらと霜が張っていました。こう寒くなってくると、自転車通学の生徒の安全が気にかかります。つるっと滑って転んだ、あの痛さは経験した人でないとわかりません。特に自転車通学者は、凍結箇所では絶対に無理をせず、必ず自転車を降りて押し歩き、安全に登校するようにしましょう。
1年国語 故事成語
故事成語の由来を調べてまとめていました。古代中国の史書や古典に由来するので、歴史の勉強としても楽しめるでしょう。


1年技術 横置き本立て
自分のペースで進めています。木材と向き合う集中力、すごいでしょう?


2年体育 バレーボール
2種類のサーブ練習。徐々に距離を遠ざけるステップを踏んで習熟していっています。


2年家庭
魚料理の実習です。しょうゆが足りなくなり、救世主が現る!よかったですね。


椎の木生活単元
入試に向けて、計算問題でよく間違えてしまうところを中心に、取り組みました。

椎の木作業
ポンポンで、受験期、みんなを励ます「◯◯」を作っています。なにかはまだ内緒です。

3年英語 単元テスト
見直しは万全でしょうか。「どこかに誤りがあるはずだ」という姿勢を忘れずに点検する習慣が、きっと受験という大舞台で生きてきます。


3年国語 久しぶりの漢字の問題
なかなか答えが思いつかない友達に、周りの人がジェスチャーで、一斉に教え始めたところが、いいなあと思いました。


私立高校の受験に向けて、3年生の多くが本格的な準備に入っています。先生方は老眼に負けじと、目を見開いて、何度も書類の点検作業をしています。一方で、インフルエンザの患者数は警報レベルを大きく超え、「サブクレードK」という変異ウイルスも確認されているそうです。感染症対策を甘く考えず、受験と学校生活を安全に進めるため、みんなで引き続き万全の対策を徹底しましょう。
1年理科 ガスバーナーの使い方
日常的に使わないから、どきどきしながら火をつけるところを見ていました。みんな度胸あるなあ。


1年社会 北アメリカ
地図を切り抜いて、ノートに貼る作業をしていました。一度経験すると形がよく分かりますね。


2年国語 ガイアの知性
ワークで内容を確認していました。問いの出され方にも気をつけて。パターンが分かってきますよ。


2年理科 電子の正体
陽子とか、中性子とか、難しいことばが出ていましたね。電子の正体。分かりましたか?

椎の木理科
演習問題をやっていました。入試対策も進めています。


3年社会 家計 経済活動
昨夜食べたアイスが、以前より1センチくらい短くなっていました。最近に物価高には閉口しています。


3年家庭 幼児のおやつを作ろう
今日はスイートポテトを作りました。担任の先生が助っ人で入ってくれて手早くできましたね。




校長室にも届けてくれました。Uさんの笑顔で、おなかも心も満足です。ごちそうさまでした!

今日はストーブの給油日です。木枯らし吹く中、ストーブ係が給油してくれました。灯油が空になり、たいへん寒い思いをするのは心も体も辛いものです。ストーブ係のみなさん、ありがとうございます。

木曜日に開館している図書室には、興味深い本を探しに生徒が訪れます。中には、「お母さんに借りてきてと頼まれました」という生徒もいます。近隣の図書館よりも、新刊や人気のある本を早く借りられるのが図書室の利点です。保護者の方までご利用いただけるとは、大変喜ばしいことです。




2年生での読み聞かせもありました。

1年体育 バレーボール
サーブ練習をしていました。うまくできている人に教わるのは、上達の早道のひとつですね。


1年数学 4章章末問題
「できたかな?」とのぞきこむのをためらってしまうくらい、みんな一生懸命に問題に向き合っていました。


2年理科 電流の正体を調べよう
電流の流れの実験をしていました。カメラが自動で反応し、赤い光を出して惑わせてしまいました。ごめんなさい。


2年社会 新しい学問と化政文化
NHK大河ドラマ「べらぼう」の舞台が化政文化の頃でしょうか。町人文化が花開いた、日本文化の原型となった活気あふれる時代です。


椎の木自立 英語「カフート」
一緒にやってみようと、そっと後ろから近づきましたが、生徒のほうが答えるのが早くて追いつけませんでした。

椎の木社会 面接練習
質問に対しての答えは、練習の成果あって、すらすら言えていたのがすごいと思いました。あとは面接官の顔をまっすぐ見て、緊張と戦う練習ですね。


3年数学 円の性質を利用していろいろな問題を解決しよう
一枚の地図を見て、いくつかの情報から、船の位置を、作図で割り出す問題に取り組んでいるところでした。


3年英語 Lesson5のまとめと復習
仮定の文の復習をしていました。「入試が終わったら~」と考えたくなるところですね。もうちょっとです。



第8回目の家庭教育学級を開催しました。講師を、片見真希先生(日本アロマ環境協会認定アロマテラピーインストラクター)にお願いし、アロマバスソルトを作りました。プレゼントにもできる素敵な仕上がりになりました。



オイルの配合など、オリジナルの、世界に一つしかないバスソルト。廊下まで漂う香りにリフレッシュ。生徒のみなさん、いつも忙しいお母様方ですから、たまには優雅なバスタイムを過ごさせてあげてくださいね。
1年美術 お面作り
美しい顔、おもしろい顔、怖い顔、いろいろあります。楽しそうです。意外と、心の内面がお面に映し出されているかも?


1年音楽 合唱「はばたこう明日へ」
卒業式に向けて、少しずつ練習を進めています。卒業式はまだ先なのですが、冬の寒さも相まって寂しさを感じます。


2年音楽 合唱「はばたこう明日へ」
男声の低音、女声の高音、しっかりとしたハーモニーを作り、1年生をリードしてください。


2年理科 静電気の性質を調べよう
風船やストローをジャージでこすって、静電気の様子を実験、観察中。バルーンアートも楽しんでいました。


椎の木作業 それぞれの課題を進めていました。受験も迫ってきましたが、毎日を大切に過ごしていきましょう。


3年音楽 リコーダー「ふるさと」
「ふるさと」はやはり名曲だと感じます。窓の外の紅葉や落ち葉と重なって、情感あふれる、まさに日本の原風景がここにあります。



3年美術 篆刻
こういう、みんなで固まってああだこうだいいながら作業を進める時間って、愛おしく感じますね。


1学年でキャリア教育「夢の懸け橋プロジェクト」を実施しました。社会人の講話を聞き、職業についての認識を深めることなどを目的としています。本日は、印西市役所クリーン推進課の山本様、印西警察署の宇治川様に講師をお願いしました。
第1部では、グループ討議を通じて意見の発表と調整を行い、その結果を先生に報告するというものでした。講師の山本様からのアドバイスをもとに、社会に出たときに求められる望ましい態度を、実践を通して体験することができました。山本様は「社会で最も必要とされる力は何か」というとても大切な問いに対し、深い考えと熱意をもってご指導くださいました。





第2部は質疑応答形式で、仕事のきっかけ、楽しさや辛さ、警察クイズなど、さまざまな話題で盛り上がりました。制服の装備も間近で見せていただき、貴重な体験となりました。講師の宇治川先生は、理想とする警察官像である「こち亀」の両さんのように親しみやすく、楽しいお話に引き込まれました。先生は、支所の丁字路で私たちの安全を見守ってくださっています。





お二人の先生、たいへんお忙しい中、私たちのために貴重な体験をありがとうございました。心より感謝申し上げます。
1年理科 アンモニアの性質を知ろう
アンモニアの噴水実験をしていました。なぜ、噴水ができるのか、みんな頭を悩ませていました。


2年国語 ガイアの知性
象と鯨(イルカ)と人間が同程度の知性を持っているという興味深い説明文です。今日は序論を読みました。


2年英語 単語の確認
丁寧に文法を確認していました。現在形と過去形との形が似つかなくなる単語はしっかり覚えましょう。


椎の木社会 地理の学習をしていました。見ただけで滋賀県だとが分かる。信楽のたぬきの知名度、すごいですね。


3年 実力テスト
校内実施の実力テストはこれで終わりですが、冬休みの頑張り次第で学力はつくし、伸びてきます。

3年理科 演習問題
実力テストの解説をしていました。「どうしたら勉強ができるようになりますか?」間違えたところはその日のうちに復習して理解する。これが最適な方法だと思います。


師走を迎えました。ALTのキッチー先生が作ってくださったクリスマスの掲示物が、ひときわ目を引いています。しかし、テレビからは「今日の気温は10月中旬並み」という予報が聞こえてきました。最近では「異常気象」という言葉自体を聞く機会も減り、もしかしたら、こうした気候の変動が新しい日常になりつつあるのかもしれません。

1年英語 Lesson5 be動詞+~ing
「今~しようと思っていたところだ」という、近い将来にも使えるそうです。便利なフレーズですね。


1年技術 横置き本立て
磨きの作業が一段落して、長さを測る作業をペアで協力して行っていました。


2年数学 二等辺三角形の性質を見つけてそれを証明しよう
三角形の合同の条件は3つ。数学は計算問題では答えがひとつに絞られますが、証明問題はいろいろアプローチできますよ。


2年家庭 豚肉の生姜焼き 野菜ソテー
2回目の調理実習。Sさんがぼそっと「なんで生姜焼きなのに、ごはんがないんだろ。」わかる!白飯と生姜焼きは最強の組み合わせですよね。


椎の木作業
ポンポン作りと、面接の答えの準備をしていました。ポンポンが大まかな体をなしてきました。


椎の木英語
よく使われるフレーズと、対義語の単語の学習でした。カードで確認しているの覚えやすいです。


3年国語
漢文の返り点の復習をしていました。明日は最後の実力テスト。頑張れ3年生。


3年保健 感染症について
インフルエンザなどの感染症が、どのようなとき、どんな経路で感染するのかを学習しました。面倒がらずに予防対策を万全に!今年の感染症は強敵です。


市内の公立小・中学校で勤務をする会計年度任用職員(非常勤職員)を募集します。1月の選考面接後、名簿登録し、令和8年4月から会計年度任用職員として採用します。
職員募集_会計年度任用職員.pdf

朝の校内を見回っていると、さまざまなタイミングで掲示物が変わっていることに気づきます。今、3年生の廊下には、学校司書の小岩井先生が、生徒たちのためにさまざまな本を選んで置いてくれています。今回見つけたのは、『めちゃ変な早口ことば』という一冊。


「路上にゾウのジョウロどうぞ」レベル5の早口ことば、皆さん、言えますか?
張り詰めた空気になりがちな受験期、ほんの少しでも生徒たちの気分をリフレッシュさせてあげたいという、小岩井先生からの温かいエールです。
1年社会 武家社会
黒板の字を一生懸命にノートに写すTさん。先生にいきなり指名されました。一瞬ヒヤッとしましたが「寝殿造です。」書きながらも、聞いていたんだ。すごい。特技?


1年技術 横置き本立て
手触りが良くなるように、紙ヤスリで磨いています。手間暇をかけた分だけ、愛着がわきます。木のぬくもりはいいですね。


2年国語 自習
職場体験学習のまとめをしていました。下級生にも発表を見せるから、文法も習ったからわかりやすく話せるように頑張りましょう。


職場体験のベストショットが並んでいます。発表会は12月9日(火)。保護者の皆様、どうぞいらしてください。

2年理科 電熱線に電流を流して生じる発熱量を求めよう
「W(ワット)」の学習をしていました。たこ足配線など、「W」の知識がないと電化製品を故障させたり、火事などを起こす危険があります。しっかり学ぼうね。


椎の木国語 漢字の学習
「難しい読みもだんだんできるようになってきたんです。」と支援員の先生が嬉しそうに話していました。継続は力なり。



3年社会 演習問題
公民のワークを進めていました。問題をたくさん解いて、慣れていきましょう。ここまで来たらどれだけ量をこなすかです。


3年数学 円周角の定理を使っていろいろな性質を導き出そう
「そういうことか~!」理解できた瞬間も嬉しいけれど、理解してもらえた瞬間も嬉しいものです。

